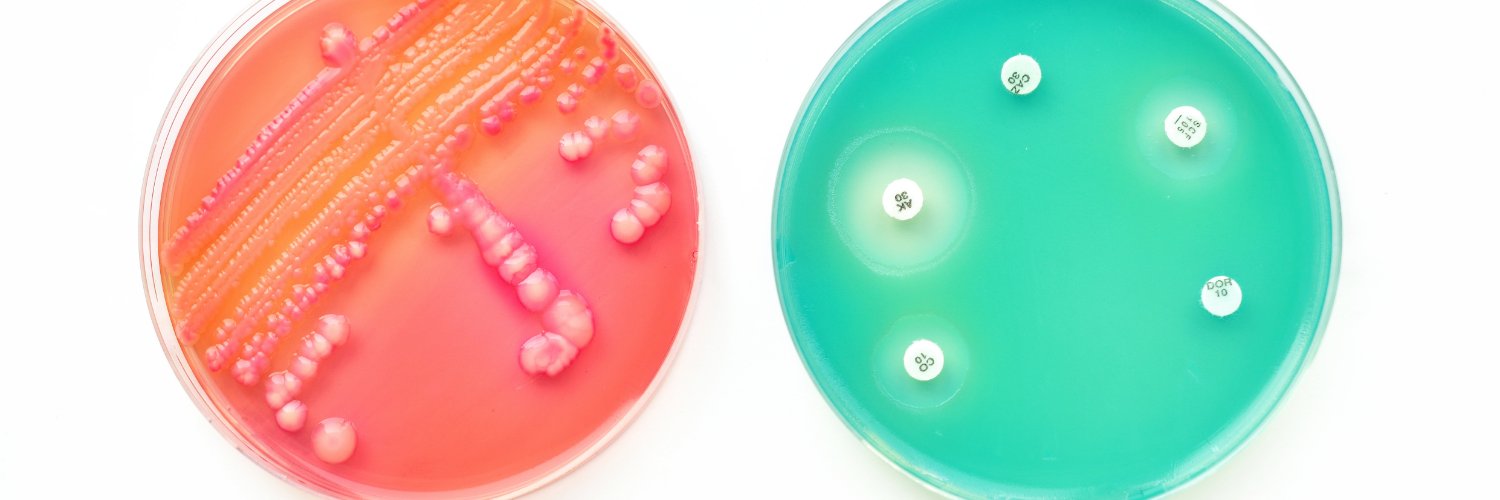
ID Genomics banner

ID Genomics
642 posts

ID Genomics
@ID_Genomics
Guiding abx prescription by matching the infecting bug with the correct drug by combining #moleculardiagnostics with epidemiological surveillance and big-data.
Seattle, WA Katılım Nisan 2016
163 Takip Edilen159 Takipçiler

November 18-24, 2021 is U.S. Antibiotic Awareness Week.
ID Genomics is committed to fight antibiotic resistance by developing precision diagnostic tests to guide antibiotic choices
Please visit our website to know more
idgenomics.com/our-products/

English

We are excited to be on the news!!
"Alongside Seattle-based ID Genomics, which Sokurenko founded, the professor’s laboratory is leading the creation and future implementation of a new method to “fingerprint” all currently known variants."
newsroom.uw.edu/resource/new-m…

English

We are thrilled to announce that we received Phase I STTR grant from National Institutes of Health (NIH) entitled “Rapid Genetic Fingerprinting of SARS-Cov-2 Variants”
#covid #sars-cov-2 #variants #fingerprinting
idgenomics.com/id-genomics-ha…

English
ID Genomics retweetledi

The perfect storm - COVID-19 underscores the need to be prepared for the next pandemic, and the pressing need for vaccines, diagnostics, antibiotics and other therapeutics to address bacterial infections and AMR. pharmatimes.com/magazine/2020/…
English
ID Genomics retweetledi

Antimicrobial resistance is the next battle ft.com/content/1f3aec… via @financialtimes
English
ID Genomics retweetledi

Special shout out to @CostalesPathMD and Dr Katherine Scribner for all their hard work running this like a boss!! 🙌🏼🙌🏼🙌🏼
Susan Butler-Wu, ☮️PhD, D(ABMM)@SBtotheDub
Today = 1 week of our #pathology resident and fellow-led volunteer COVID Collection Team doing their thing!! I’m so proud of these guys stepping up big time - so lucky to have such wonderful trainees here @LACUSCMedCenter 🙏😄@CostalesPathMD
English
ID Genomics retweetledi

Coronavirus lessons for the fight against ‘superbugs’ ft.com/content/84f504… via @financialtimes
English

IDG is in the same race - we are developing rapid, cheap and simple diagnostics for bacterial infections.
CARB-X@CARB_X
New Genomic Tests Aim to Diagnose Deadly Infections Faster nyti.ms/2SVTw7S
English

Epidemiological surveillance database BactNeT developed at IDG, is a perfect tool for hospital Antibiotic Stewardship programs. idgenomics.com/our-products/b…
#USAAW19 #BeAntibioticsAware
English
ID Genomics retweetledi

#Antibiotics are one of the most powerful tools we have to fight infections. But they can cause side effects and can lead to #AntibioticResistance. This #USAAW19, learn more about when abx are and aren’t needed so you can #BeAntibioticsAware. bit.ly/2WaZ5ya
English

#USAAW19 #BeAntibioticsAware Check out how our diagnostic platform can improve antibiotic prescription practices idgenomics.com/our-products/
English
ID Genomics retweetledi

Interesting background on how a new study is to test #AntibioticResistance in marine mammals hcn.org/articles/ocean…
English

Great Friday meme, but also so true! Enjoy your weekend :)
Battle Superbugs ☮️@battlesuperbugs
Brilliant.
English
ID Genomics retweetledi

Our latest newsletter is kind of awesome and we're pretty excited about it - check it out! And please share! mailchi.mp/a2ef7b00c872/a…

English

IDG Team is proud to announce the completion of the first Pre-Submission meeting with the FDA for the CLoNeT E. coli Assay for Urinary Tract Infections (UTIs).
prnewswire.com/news-releases/…
English

Simple infections become more resistant to antibiotics. IDGenomics develops a rapid diagnostic test to detect UTI pathogen, predict its antibiotic susceptibility in under an hour for a more precise antibiotic prescription.
wbur.org/hereandnow/201…
English



